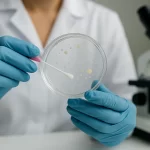

What Is the Emma Test?
The Emma Test is a uterine microbiota analysis designed to evaluate the balance of beneficial and harmful bacteria inside the uterus. This balance plays a crucial role in fertility, embryo implantation, and pregnancy outcomes.
An imbalance in the uterine microbiota can reduce the chances of embryo implantation and increase the risk of miscarriage. By analyzing these bacterial communities, the Emma Test helps doctors create a personalized treatment plan, especially for women undergoing IVF (in vitro fertilization).
How Is the Emma Test Performed?
The Emma Test is a quick and relatively simple procedure. Here are the main steps:
-
Sample Collection: A gynecologist collects a small sample from the uterine lining.
-
Laboratory Analysis: The sample is sent to the lab, where advanced microbiological analysis is conducted.
-
Detailed Report: The test report shows the bacterial composition, balance, and presence of harmful bacteria.
-
Personalized Treatment Plan: Based on the results, the doctor may recommend antibiotics, probiotics, or other supportive treatments.
The procedure is safe, usually painless, and performed in a clinical setting.
Who Should Consider the Emma Test?
The Emma Test is not a routine examination but is highly recommended in the following cases:
-
Repeated IVF failures
-
Unexplained infertility
-
Recurrent pregnancy loss
-
Embryo implantation issues
For women experiencing these challenges, the Emma Test can significantly increase the chances of a successful pregnancy.
What Do the Emma Test Results Mean?
The results indicate the bacterial balance in the uterus:
-
Normal microbiota: Suitable conditions for embryo implantation.
-
Imbalanced microbiota: Probiotic or medical support may be required.
-
High levels of harmful bacteria: Antibiotic treatment may be necessary.
Results should always be interpreted by a qualified gynecologist.
The Emma Test is an innovative diagnostic tool that enhances reproductive treatment strategies. For women struggling with infertility, IVF failure, or recurrent miscarriages, this test can play a vital role in improving pregnancy outcomes.
